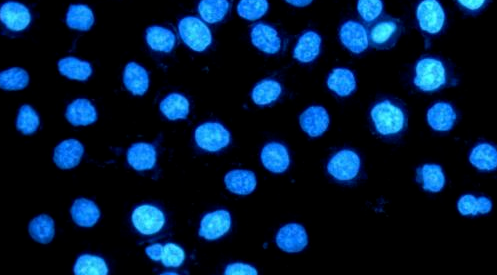

以创新为生存之源,以质量为发展之本,为生命科学事业发展,贡献一份力量!
丰渺生物
Cmvbio
Engineered to move the human spirit! The Relentless Pursuit of Perfection! No business too small, no problem too big.
PRODUCT / 产品详情
产品规格:
| 货号: | C2902 |
| 规格: | 10mL |
| 价格: | ¥680.00 |
Hoechst 33342活细胞染色液,是一种适用于活细胞细胞核染色的溶液。仅需染色10分钟就能用荧光显微镜观察到非常明亮的细胞核蓝色荧光染色。本产品也适用于固定后的细胞或组织的细胞核染色。Hoechst 33342分子式为C27H28N6O·3HCl·3H2O,分子量为615.99,CAS Number 23491-52-3。Hoechst 33342的最大激发波长为346nm,最大发射波长为460nm;Hoechst 33342和双链DNA结合后,最大激发波长为350nm,最大发射波长为460nm。Hoechst 33342是一种可以穿透细胞膜的蓝色荧光染料,对细胞的毒性较低;常用于细胞凋亡检测,染色后用荧光显微镜观察或流式细胞仪检测;也常用于普通的细胞核染色,或常规的DNA染色。
存储条件:
-20℃避光保存,一年有效。
案例分析:
| 货号 | 产品名称 | 规格 | 价格 |
| C2901 | DAPI染色液 | 10mL | ¥680.00 |
| C2902 | Hoechst33342染色液 | 10mL | ¥680.00 |
| C2903 | Propidium Iodide-碘化丙啶 | 10mL | ¥680.00 |
| C2904 | Green488活细胞核染料 | 10mL | ¥680.00 |
| C2905 | Green488死细胞核染料 | 10mL | ¥680.00 |
| C2906 | EMA-叠氮溴化乙锭 | 5mL | ¥2,680.00 |
| C2907 | EthD-I | 1mg | ¥2,860.00 |
| C2908 | Green live-cell nucleic acid stain绿色活细胞核酸染料 | 1mL | ¥960.00 |
| C2909 | Green dead-cell nucleic acid stain死细胞绿色荧光染料 | 1mL | ¥960.00 |
| C2910 | Acridine orange-吖啶橙 | 1mL | ¥260.00 |
| C2911 | DRAQ5-远红外荧光活细胞 DNA 染料 | 50μL | ¥2,200.00 |
| C2912 | Calcein blue AM-钙黄绿素蓝乙酰甲酯 | 1mg | ¥1,600.00 |
| C2913 | Calcein AM-钙黄绿素乙酰甲酯 | 1mg | ¥2,200.00 |
| C2914 | BCECF AM-pH荧光探针,细胞质 | 1mg | ¥2,100.00 |
| C2915 | CFDA SE-细胞增殖示踪 | 25mg | ¥1,800.00 |
| C2916 | CDCFDA SE-活细胞荧光示踪 | 25mg | ¥1,800.00 |
| C2917 | CellMaker Blue CMAC-细胞质示踪蓝色荧光 | 5mg | ¥2,100.00 |
| C2918 | CellMaker Green CMFDA-细胞质示踪绿色荧光 | 1mg | ¥2,200.00 |
| C2919 | Monobromobimane (mBBr)-单溴二胺 | 25mg | ¥1,200.00 |
| C2920 | DiO perchlorate-细胞膜绿色荧光 | 25mg | ¥2,200.00 |
| C2921 | Dil perchlorate-细胞膜橙红色荧光 | 25mg | ¥2,200.00 |
| C2922 | DiD perchlorate-细胞膜红色荧光 | 25mg | ¥2,200.00 |
| C2923 | DiR iodide-细胞膜紫红色荧光 | 10mg | ¥2,200.00 |
| C2924 | 聚醚多元醇-细胞加载染料增强剂 | 1mL | ¥560.00 |
| C2925 | MitoMaker Orange CMTMRos-线粒体橙色荧光 | 1mL | ¥2,100.00 |
| C2926 | MitoMaker Red CMXRos-线粒体红色荧光 | 1mL | ¥1,800.00 |
| C2927 | Rhodamine 123-罗丹明 123 | 25mg | ¥1,800.00 |
| C2928 | JC-1 Mitochondrial Potential Probe-线粒体荧光探针) | 1mg | ¥2,100.00 |
| C2929 | Dihydrorhodamine 123-二氢罗丹明 123 | 10mg | ¥2,100.00 |
| C2930 | JC-1线粒体膜电位检测试剂盒 | 100T | ¥960.00 |
| C2931 | JC-10线粒体膜电位检测试剂盒 | 100T | ¥960.00 |
| C2932 | LysoView Blue-溶酶体蓝色荧光 | 1mL | ¥1,800.00 |
| C2933 | LysoView Green-溶酶体绿色荧光 | 1mL | ¥1,800.00 |
| C2934 | NBD C6-Ceramide-高尔基体荧光 | 1mg | ¥2,200.00 |
| C2935 | DiOC6(3)-内质网绿色荧光 | 25mg | ¥1,800.00 |
| C2936 | ActinGreen 488 Probes-细胞骨架绿色荧光 | 5mL | ¥2,200.00 |
| C2937 | ActinRed 555 Probes-细胞骨架红色荧光 | 5mL | ¥2,200.00 |








